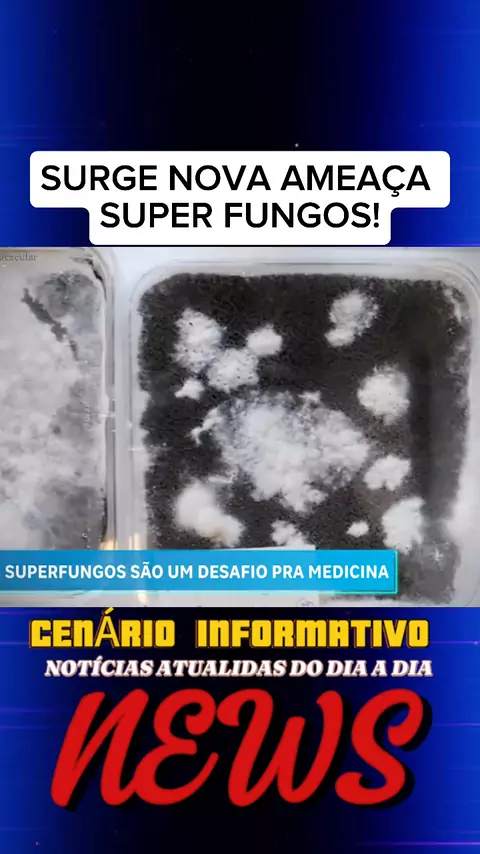

CENÁRIO INFORMATIVO

177
Publicaciones

Todas las listas de reproducción · Total 13

2
EQUIPE DE RESGATE DA INDONÉSIA TENTAM RECUPERAR NESTA QUARTA-FEIRA O CORPO DE JULIANA MARTINS #JulianaMartins #brasileira #vulcao #indonesia #noticias

2
MOMENTO DO RESGATE DA JULIANA MARINS DO VULCÃO #JulianaMarins #resgate #vulcao #noticias #viral

3
ATAQUE ISRAELENSE ESTOURA CANO E ALAGA RUA DE TEERÃ #Noticias #iran #israel #guerra

64
SARGENTO ACABA COM O SONHO DA EX #sargento #morte #ex #mulher #noticia

2
O DRAMA DAS FAMÍLIAS QUE VIVEM PERTO DAS TORRES DE ENERGIA EÓLICA #noticias #jornalismo #informacao #news

2
PROJETO DE LEI PARA ACABAR COM O DINHEIRO EM PAPEL #noticias #jornalismo #informacao #dinheiro

2
IDOSA É ASSASSINADA PELO PRÓPRIO NETO #noticia #assassinato #morte #idosa

2
ENTREVISTA COM FERNANDINHO BEIRAMAR #fernadinhobeiramar #entrvista #noticias

2
VIRGÍNIA FONSECA PARTICIPA DA CPI DAS BETS #virginia #noticia #tereza
2
NOVA AMEAÇA DOS FUNGOS #fungos #bacterias #superfungos #noticias

3
O DNA DE DEUS FOI ENCONTRADO #noticia #dna #news #Deus

2
LULA NEGA PEDIDO DE TRUMP EM CLASSIFICAR PCC E COMANDO VERMELHO COM TERRORISTAS #lula #trump #facção #noticia #terrorismo

5
TUDO PRONTO INICIA O CONCLAVE ENTRE DOIS A TRÊS DIA IGREJA CATÓLICA TERÁ NOVO PAPA #conclave #Religião #noticia #news #papa






















